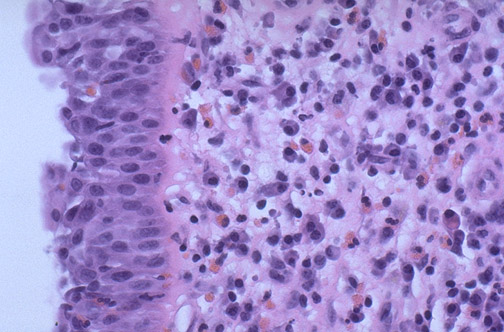

| A form of localized anaphylaxis with type I hypersensitivity occurs with "hay fever" when allergens in plant pollens contact IgE bound to mast cells, causing them to release their granules containing mediators such as histamine that promote vasodilation and edema. Beneath the nasal mucosa at the left, eosinophils have been attracted. The plasma cells seen here have collected due to the chronic nature of the antigenic stimulation. |
![]() |